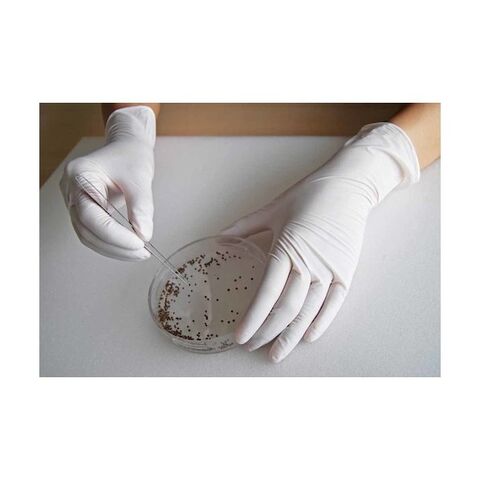

1/3
時点_ポイント最大11倍
ショーワグローブ No884ニトリスト L ホワイト 1箱
販売価格
1,438
円 (税込)
- 出荷目安:
- 本日出荷(15時まで/土日祝も出荷)
たまるdポイント(通常) 13
+キャンペーンポイント(期間・用途限定) 最大10倍
※たまるdポイントはポイント支払を除く商品代金(税抜)の1%です。
※表示倍率は各キャンペーンの適用条件を全て満たした場合の最大倍率です。
各キャンペーンの適用状況によっては、ポイントの進呈数・付与倍率が最大倍率より少なくなる場合がございます。
dカードでお支払ならポイント3倍
各キャンペーンの適用状況によっては、ポイントの進呈数・付与倍率が最大倍率より少なくなる場合がございます。
- 商品情報
- レビュー
特徴
●厚みがあり、機械加工・整備などのハードな作業でもお使い頂けます。
●指先に細かな凹凸をつけることで、油や水に濡れたものに対しても優れたすべり止め効果を発揮します。
●食品加工業。
●弱電機械工業。
●色:ホワイト
●サイズ:L
●厚さ(mm):約0.1
●全長(cm):24.0
●手のひら周り(cm):21.0
●中指長さ(cm):8.3
●粉:なし
●食品衛生法適合品
●左右兼用
●ニトリルゴム(NBR)
仕様
| サイズ | L | カラー | ホワイト |
| 入数 | 1箱 | 原産国 | マレーシア |